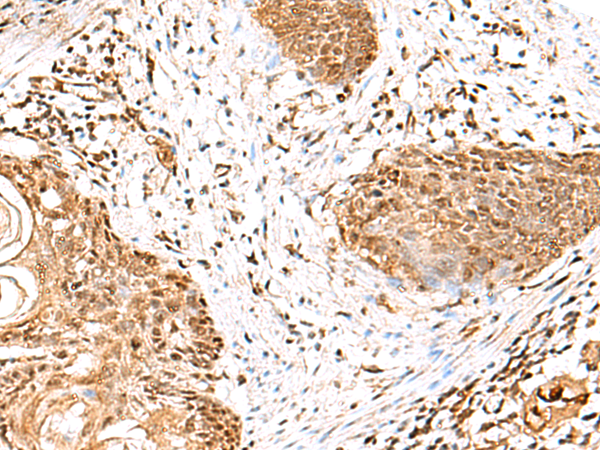

-
分类: 科研抗体货号: P10100别名: PDIP1; FKSG86; BACURD1; POLDIP1; hBACURD1应用: IHC反应种属: Human, Mouse
-
分类: 科研抗体货号: P10099别名: C21orf95应用: IHC反应种属: Human, Mouse
-
分类: 科研抗体货号: P10122别名: AYST720; PRO1385应用: WB,IHC反应种属: Human, Mouse, Rat
-
分类: 科研抗体货号: P10098别名: HPXEL应用: WB,IHC反应种属: Human, Rat
-
分类: 科研抗体货号: P10138别名: ET应用: WB,IHC反应种属: Human, Mouse, Rat
-
分类: 科研抗体货号: P10121别名:应用: WB,IHC反应种属: Human, Mouse
-
分类: 科研抗体货号: P10097别名: AAKG; CMH6; WPWS; AAKG2; H91620p应用: WB,IHC反应种属: Human, Mouse
-
分类: 科研抗体货号: P10136别名: VATC; Vma5; ATP6C; ATP6D应用: WB,IHC反应种属: Human, Mouse, Rat
-
分类: 科研抗体货号: P10119别名: MDDGA14; MDDGB14; MDDGC14应用: WB,IHC反应种属: Human, Mouse
-
分类: 科研抗体货号: P10096别名: NET14; WDC146应用: IHC反应种属: Human, Mouse

鄂公网安备42018502007531号
鄂公网安备42018502007531号

